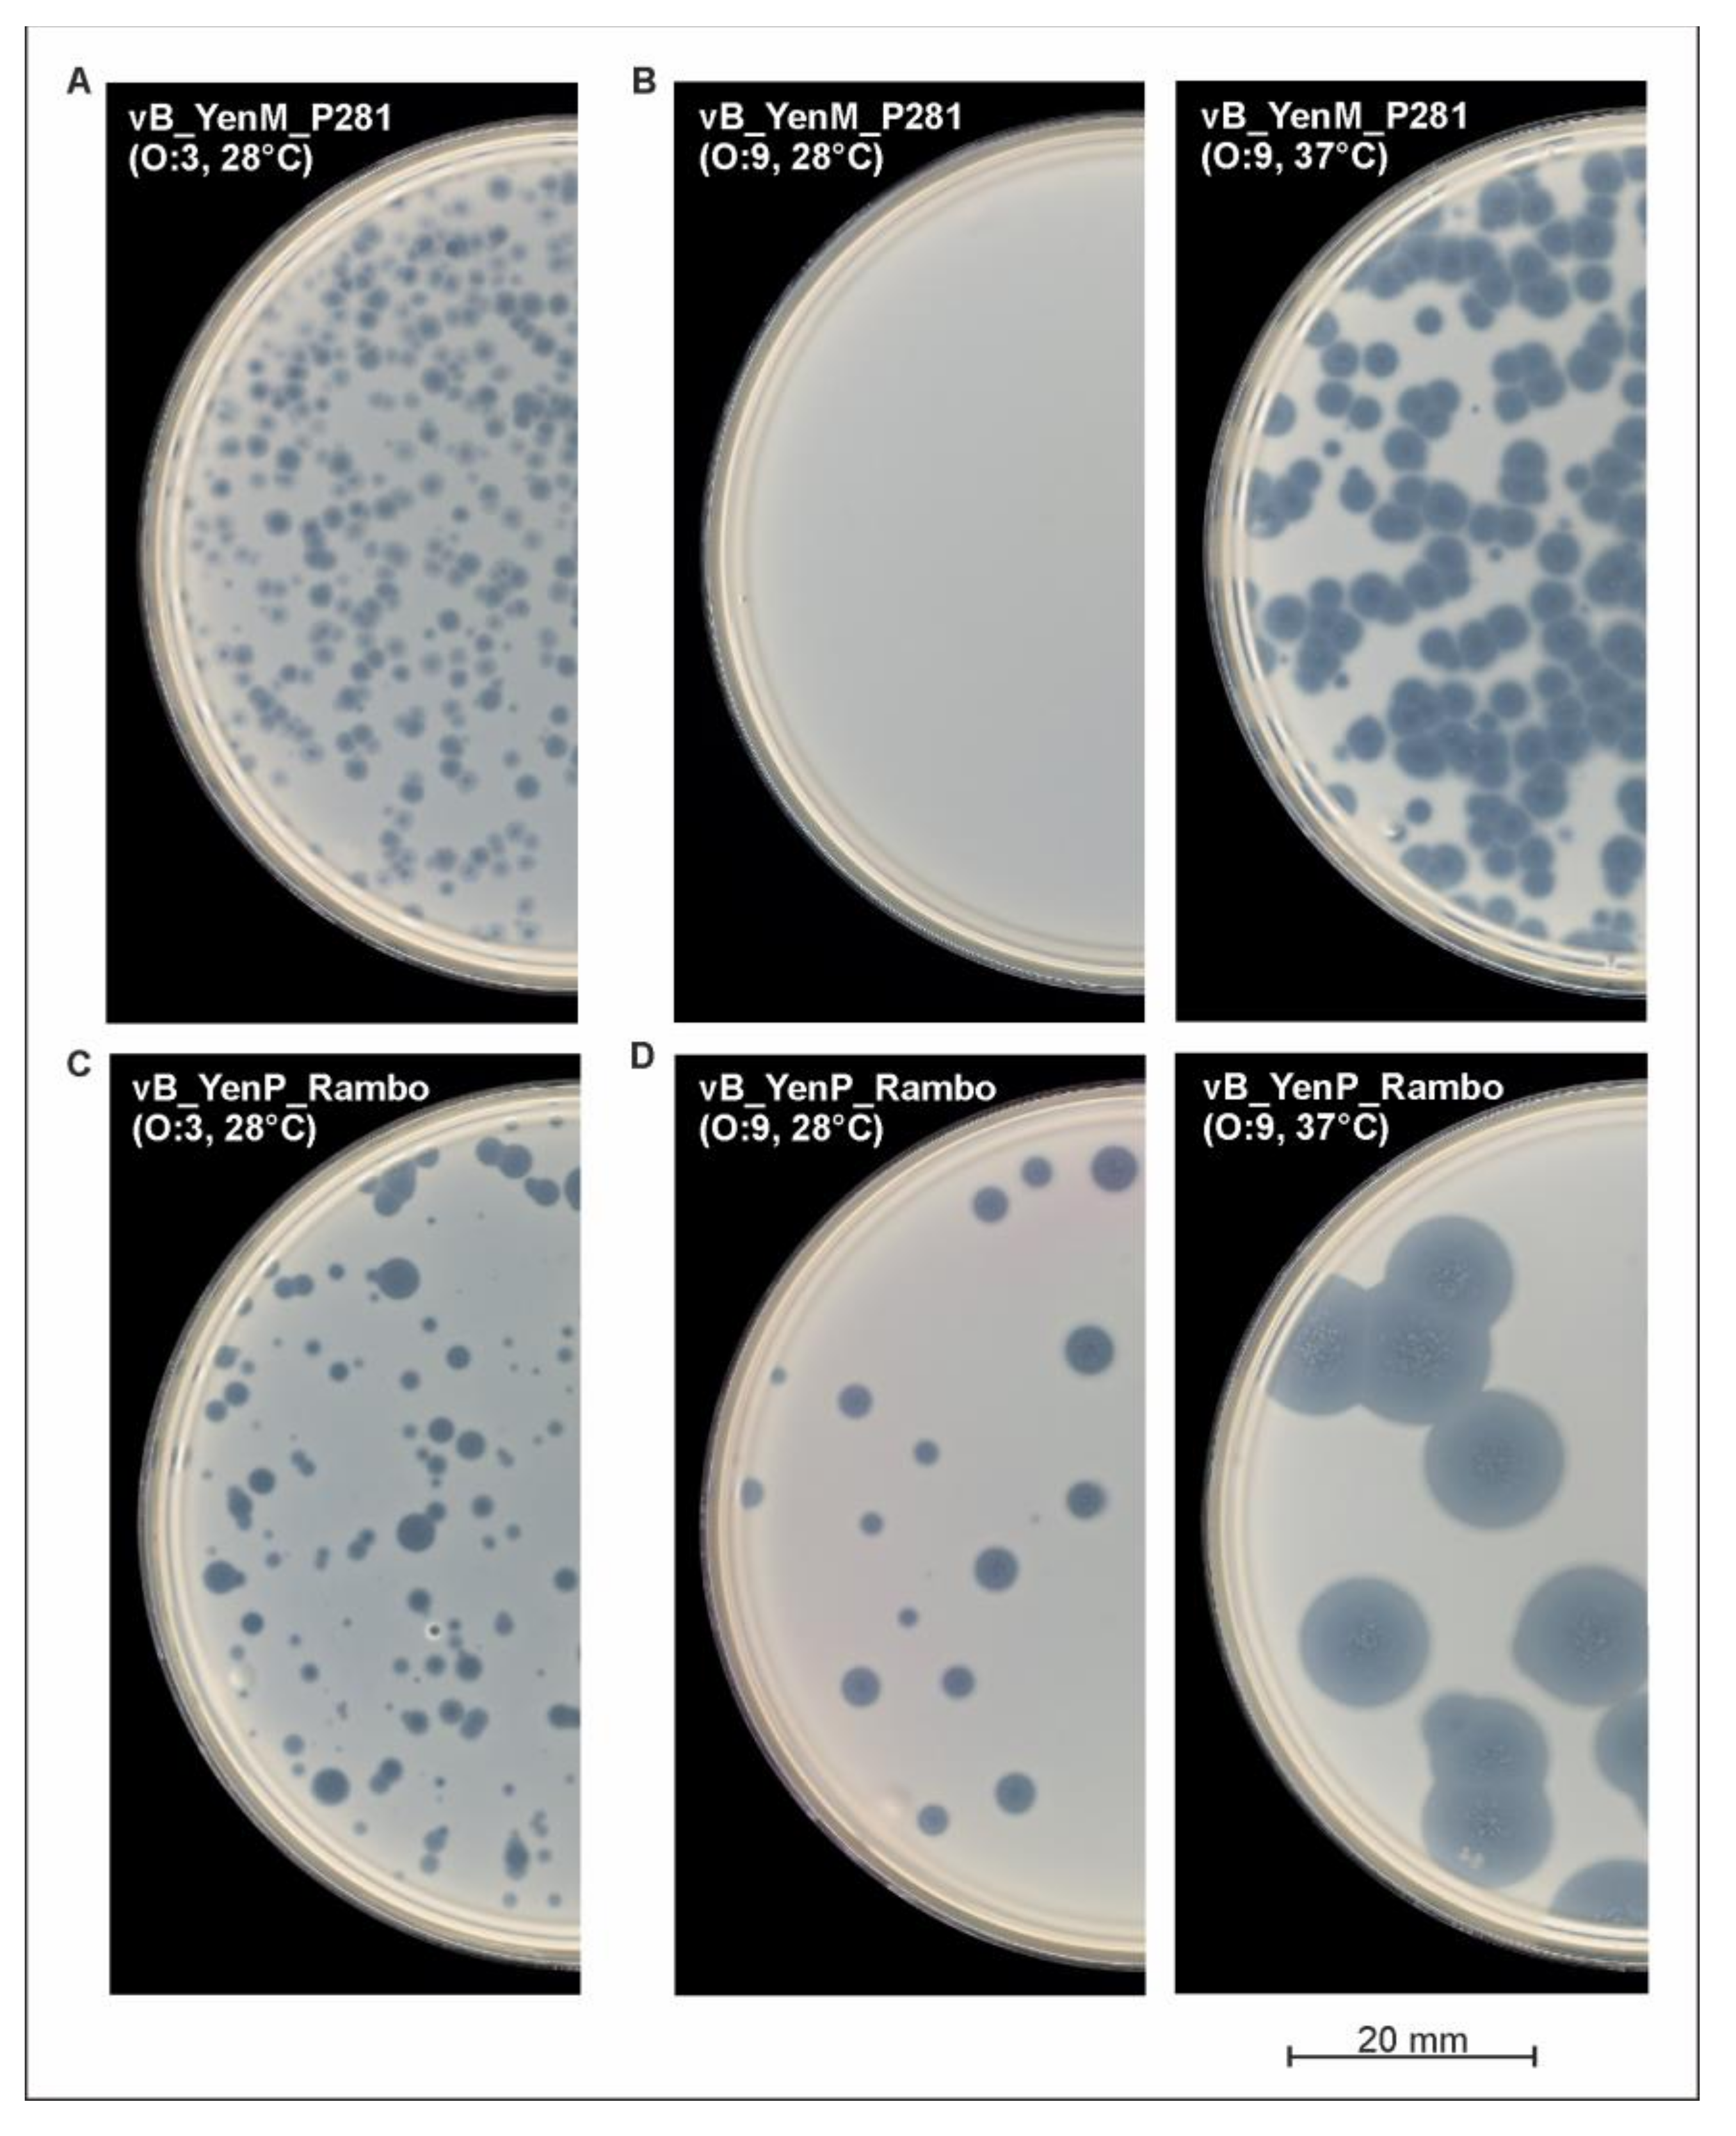
Ijms 22 11381 g004 Ijms 22 11381 g004

Properties of Two Broad Host Range Phages of Yersinia enterocolitica Isolated from Wild Animals
Abstract
1. Introduction
2. Results
2.1. The Phages Isolated from Game Exhibit Podovirus and Myovirus Morphology
2.2. vB_YenP_Rambo and vB_YenM_P281 Are Related to Known Phages
2.3. Phage vB_YenP_Rambo and vB_YenM_P281 Exhibited a Broad Host Range
2.4. Lysis of Y. pseudotuberculosis by vB_YenM_P281 and PY100 Depends on the Presence of Calcium and Magnesium Cations
2.5. The Phages vB_YenP_Rambo and vB_YenM_P281 Show a Strong Lytic Activity
3. Discussion
4. Materials and Methods
4.1. Bacterial Strains and Culture Conditions
4.2. Isolation, Propagation and Purification of Phages
4.3. Host Range Determination
4.4. Transmission Electron Microscopy (TEM)
4.5. Phage DNA Preparation, Sequencing and Genome Annotation
4.6. Nucleotide Sequencing Data
5. Conclusions
Supplementary Materials
Author Contributions
Funding
Institutional Review Board Statement
Informed Consent Statement
Data Availability Statement
Acknowledgments
Conflicts of Interest
References
- Le Guern, A.S.; Martin, L.; Savin, C.; Carniel, E. Yersiniosis in France: Overview and potential sources of infection. Int. J. Infect. Dis. 2016, 46, 1–7. [Google Scholar] [CrossRef]
- European Food Safety Authority ECfDPaC. The European Union summary report on trends and sources of zoonoses, zoonotic agents and food-borne outbreaks in 2014. EFSA J. 2015, 13, 4329–4520. [Google Scholar]
- Bancerz-Kisiel, A.; Szweda, W. Yersiniosis-A zoonotic foodborne disease of relevance to public health. Ann. Agric. Environ. Med. 2015, 22, 397–402. [Google Scholar] [CrossRef] [PubMed]
- Fredriksson-Ahomaa, M.; Stolle, A.; Korkeala, H. Molecular epidemiology of Yersinia enterocolitica infections. FEMS Immunol. Med. Microbiol. 2006, 47, 315–329. [Google Scholar] [CrossRef] [PubMed]
- Fredriksson-Ahomaa, M.; Stolle, A.; Siitonen, A.; Korkeala, H. Sporadic human Yersinia enterocolitica infections caused by bioserotype 4/O: 3 originate mainly from pigs. J. Med. Microbiol. 2006, 55 Pt 6, 747–749. [Google Scholar] [CrossRef]
- Laukkanen, R.; Martinez, P.O.; Siekkinen, K.M.; Ranta, J.; Maijala, R.; Korkeala, H. Transmission of Yersinia pseudotuberculosis in the pork production chain from farm to slaughterhouse. Appl. Environ. Microbiol. 2008, 74, 5444–5450. [Google Scholar] [CrossRef] [PubMed][Green Version]
- Jamali, H.; Paydar, M.; Radmehr, B.; Ismail, S. Prevalence, characterization, and antimicrobial resistance of Yersinia species and Yersinia enterocolitica isolated from raw milk in farm bulk tanks. J. Dairy Sci. 2015, 98, 798–803. [Google Scholar] [CrossRef] [PubMed]
- MacDonald, E.; Einoder-Moreno, M.; Borgen, K.; Thorstensen Brandal, L.; Diab, L.; Fossli, O.; Herrador, B.G.; Hassan, A.A.; Johannessen, G.S.; Johansen, E.J.; et al. National outbreak of Yersinia enterocolitica infections in military and civilian populations associated with consumption of mixed salad, Norway, 2014. Euro Surveill. 2016, 21, 30321. [Google Scholar] [CrossRef] [PubMed]
- Terech-Majewska, E.; Pajdak, J.; Platt-Samoraj, A.; Szczerba-Turek, A.; Bancerz-Kisiel, A.; Grabowska, K. Characterization of Yersinia enterocolitica strains potentially virulent for humans and animals in river water. J. Appl. Microbiol. 2016, 121, 554–560. [Google Scholar] [CrossRef] [PubMed]
- Cilia, G.; Turchi, B.; Fratini, F.; Bilei, S.; Bossu, T.; De Marchis, M.L.; Cerri, D.; Pacini, M.I.; Bertelloni, F. Prevalence, Virulence and Antimicrobial Susceptibility of Salmonella spp., Yersinia enterocolitica and Listeria monocytogenes in European Wild Boar (Sus scrofa) Hunted in Tuscany (Central Italy). Pathogens 2021, 10, 93. [Google Scholar] [CrossRef]
- Syczylo, K.; Platt-Samoraj, A.; Bancerz-Kisiel, A.; Szczerba-Turek, A.; Pajdak-Czaus, J.; Labuc, S.; Procajło, Z.; Socha, P.; Chuzhebayeva, G.; Szweda, W. The prevalence of Yersinia enterocolitica in game animals in Poland. PLoS ONE 2018, 13, e0195136. [Google Scholar] [CrossRef] [PubMed]
- Bancerz-Kisiel, A.; Pieczywek, M.; Lada, P.; Szweda, W. The Most Important Virulence Markers of Yersinia enterocolitica and Their Role during Infection. Genes (Basel) 2018, 9, 235. [Google Scholar] [CrossRef]
- Joutsen, S.; Eklund, K.M.; Laukkanen-Ninios, R.; Stephan, R.; Fredriksson-Ahomaa, M. Sheep carrying pathogenic Yersinia enterocolitica bioserotypes 2/O:9 and 5/O:3 in the feces at slaughter. Vet. Microbiol. 2016, 197, 78–82. [Google Scholar] [CrossRef][Green Version]
- Moorman, V.R.; Cohen, J.I. Insights into the individual evolutionary origins of Yersinia virulence factor effector proteins. Plasmid 2021, 114, 102562. [Google Scholar] [CrossRef] [PubMed]
- Bolton, D.J.; Ivory, C.; McDowell, D. Thermal inactivation of Yersinia enterocolitica in pork slaughter plant scald tank water. Meat Sci. 2013, 95, 668–671. [Google Scholar] [CrossRef]
- Nesbakken, T.; Nerbrink, E.; Rotterud, O.J.; Borch, E. Reduction of Yersinia enterocolitica and Listeria spp. on pig carcasses by enclosure of the rectum during slaughter. Int. J. Food Microbiol. 1994, 23, 197–208. [Google Scholar] [CrossRef]
- Van Damme, I.; Berkvens, D.; Vanantwerpen, G.; Bare, J.; Houf, K.; Wauters, G.; De Zutter, L. Contamination of freshly slaughtered pig carcasses with enteropathogenic Yersinia spp.: Distribution, quantification and identification of risk factors. Int. J. Food Microbiol. 2015, 204, 33–40. [Google Scholar] [CrossRef]
- Xu, Y. Phage and phage lysins: New era of bio-preservatives and food safety agents. J. Food Sci. 2021, 86, 3349–3373. [Google Scholar] [CrossRef]
- Gwak, K.M.; Choi, I.Y.; Lee, J.; Oh, J.H.; Park, M.K. Isolation and Characterization of a Lytic and Highly Specific Phage against Yersinia enterocolitica as a Novel Biocontrol Agent. J. Microbiol. Biotechnol. 2018, 28, 1946–1954. [Google Scholar] [CrossRef]
- Salem, M.; Skurnik, M. Genomic Characterization of Sixteen Yersinia enterocolitica-Infecting Podoviruses of Pig Origin. Viruses 2018, 10, 174. [Google Scholar] [CrossRef]
- Salem, M.; Virtanen, S.; Korkeala, H.; Skurnik, M. Isolation and characterization of Yersinia-specific bacteriophages from pig stools in Finland. J. Appl. Microbiol. 2015, 118, 599–608. [Google Scholar] [CrossRef] [PubMed]
- Skurnik, M. Yersinia surface structures and bacteriophages. Adv. Exp. Med. Biol. 2012, 954, 293–301. [Google Scholar]
- Hammerl, J.A.; Klein, I.; Appel, B.; Hertwig, S. Interplay between the temperate phages PY54 and N15, linear plasmid prophages with covalently closed ends. J. Bacteriol. 2007, 189, 8366–8370. [Google Scholar] [CrossRef]
- Hertwig, S.; Klein, I.; Appel, B. Properties of the temperate Yersinia enterocolitica bacteriophage PY54. Adv. Exp. Med. Biol. 2003, 529, 241–243. [Google Scholar]
- Hertwig, S.; Klein, I.; Lurz, R.; Lanka, E.; Appel, B. PY54, a linear plasmid prophage of Yersinia enterocolitica with covalently closed ends. Mol. Microbiol. 2003, 48, 989–1003. [Google Scholar] [CrossRef] [PubMed]
- Hertwig, S.; Klein, I.; Schmidt, V.; Beck, S.; Hammerl, J.A.; Appel, B. Sequence analysis of the genome of the temperate Yersinia enterocolitica phage PY54. J. Mol. Biol. 2003, 331, 605–622. [Google Scholar] [CrossRef]
- Leon-Velarde, C.G.; Jun, J.W.; Skurnik, M. Yersinia Phages and Food Safety. Viruses 2019, 11, 1105. [Google Scholar] [CrossRef] [PubMed]
- Leon-Velarde, C.G.; Kropinski, A.M.; Chen, S.; Abbasifar, A.; Griffiths, M.W.; Odumeru, J.A. Complete genome sequence of bacteriophage vB_YenP_AP5 which infects Yersinia enterocolitica of serotype O:3. Virol. J. 2014, 11, 188. [Google Scholar] [CrossRef] [PubMed]
- Liang, J.; Li, X.; Zha, T.; Chen, Y.; Hao, H.; Liu, C.; Duan, R.; Xiao, Y.; Su, M.; Wang, X.; et al. DTDP-rhamnosyl transferase RfbF, is a newfound receptor-related regulatory protein for phage phiYe-F10 specific for Yersinia enterocolitica serotype O:3. Sci. Rep. 2016, 6, 22905. [Google Scholar] [CrossRef] [PubMed]
- Pajunen, M.I.; Kiljunen, S.J.; Soderholm, M.E.; Skurnik, M. Complete genomic sequence of the lytic bacteriophage phiYeO3-12 of Yersinia enterocolitica serotype O:3. J. Bacteriol. 2001, 183, 1928–1937. [Google Scholar] [CrossRef] [PubMed]
- Jun, J.W.; Park, S.C.; Wicklund, A.; Skurnik, M. Bacteriophages reduce Yersinia enterocolitica contamination of food and kitchenware. Int. J. Food Microbiol. 2018, 271, 33–47. [Google Scholar] [CrossRef] [PubMed]
- Kiljunen, S.; Vilen, H.; Pajunen, M.; Savilahti, H.; Skurnik, M. Nonessential genes of phage phiYeO3-12 include genes involved in adaptation to growth on Yersinia enterocolitica serotype O:3. J. Bacteriol. 2005, 187, 1405–1414. [Google Scholar] [CrossRef]
- Leon-Velarde, C.G.; Happonen, L.; Pajunen, M.; Leskinen, K.; Kropinski, A.M.; Mattinen, L.; Rajtor, M.; Zur, J.; Smith, D.; Chen, S.; et al. Yersinia enterocolitica-Specific Infection by Bacteriophages TG1 and varphiR1-RT Is Dependent on Temperature-Regulated Expression of the Phage Host Receptor OmpF. Appl. Environ. Microbiol. 2016, 82, 5340–5353. [Google Scholar] [CrossRef] [PubMed]
- Schwudke, D.; Ergin, A.; Michael, K.; Volkmar, S.; Appel, B.; Knabner, D.; Konietzny, A.; Strauch, E. Broad-host-range Yersinia phage PY100: Genome sequence, proteome analysis of virions, and DNA packaging strategy. J. Bacteriol. 2008, 190, 332–342. [Google Scholar] [CrossRef]
- Xue, Y.; Zhai, S.; Wang, Z.; Ji, Y.; Wang, G.; Wang, T.; Wang, X.; Xi, H.; Cai, R.; Zhao, R.; et al. The Yersinia Phage X1 Administered Orally Efficiently Protects a Murine Chronic Enteritis Model Against Yersinia enterocolitica Infection. Front. Microbiol. 2020, 11, 351. [Google Scholar] [CrossRef]
- Garcia, E.; Elliott, J.M.; Ramanculov, E.; Chain, P.S.; Chu, M.C.; Molineux, I.J. The genome sequence of Yersinia pestis bacteriophage phiA1122 reveals an intimate history with the coliphage T3 and T7 genomes. J. Bacteriol. 2003, 185, 5248–5262. [Google Scholar] [CrossRef]
- Garcia-Doval, C.; van Raaij, M.J. Crystallization of the C-terminal domain of the bacteriophage T7 fibre protein gp17. Acta Crystallogr. Sect. F Struct. Biol. Cryst. Commun. 2012, 68, 166–171. [Google Scholar] [CrossRef]
- Pajunen, M.; Kiljunen, S.; Skurnik, M. Bacteriophage phiYeO3-12, specific for Yersinia enterocolitica serotype O:3, is related to coliphages T3 and T7. J. Bacteriol. 2000, 182, 5114–5120. [Google Scholar] [CrossRef] [PubMed]
- Wichels, A.; Biel, S.S.; Gelderblom, H.R.; Brinkhoff, T.; Muyzer, G.; Schutt, C. Bacteriophage diversity in the North Sea. Appl. Environ. Microbiol. 1998, 64, 4128–4133. [Google Scholar] [CrossRef]
- Bari, M.L.; Hossain, M.A.; Isshiki, K.; Ukuku, D. Behavior of Yersinia enterocolitica in Foods. J. Pathog. 2011, 2011, 420732. [Google Scholar] [CrossRef] [PubMed]
- Capra, M.L.; Del, L.Q.A.; Ackermann, H.W.; Moineau, S.; Reinheimer, J.A. Characterization of a new virulent phage (MLC-A) of Lactobacillus paracasei. J. Dairy Sci. 2006, 89, 2414–2423. [Google Scholar] [CrossRef]
- Islam, M.R.; Ogura, Y.; Asadulghani, M.; Ooka, T.; Murase, K.; Gotoh, Y.; Hayashi, T. A sensitive and simple plaque formation method for the Stx2 phage of Escherichia coli O157:H7, which does not form plaques in the standard plating procedure. Plasmid 2012, 67, 227–235. [Google Scholar] [CrossRef]
- Li, E.; Yin, Z.; Ma, Y.; Li, H.; Lin, W.; Wei, X.; Zhao, R.; Jiang, A.; Yuan, J.; Zhao, X. Identification and molecular characterization of bacteriophage phiAxp-2 of Achromobacter xylosoxidans. Sci Rep. 2016, 6, 34300. [Google Scholar] [CrossRef] [PubMed]
- Hammerl, J.A.; Klein, I.; Lanka, E.; Appel, B.; Hertwig, S. Genetic and functional properties of the self-transmissible Yersinia enterocolitica plasmid pYE854, which mobilizes the virulence plasmid pYV. J. Bacteriol. 2008, 190, 991–1010. [Google Scholar] [CrossRef] [PubMed]
- Jäckel, C.; Hammerl, J.A.; Reetz, J.; Kropinski, A.M.; Hertwig, S. Campylobacter group II phage CP21 is the prototype of a new subgroup revealing a distinct modular genome organization and host specificity. BMC Genom. 2015, 16, 629. [Google Scholar] [CrossRef] [PubMed]
- Jäckel, C.; Hertwig, S.; Scholz, H.C.; Nöckler, K.; Reetz, J.; Hammerl, J.A. Prevalence, host range, and comparative genomic analysis of temperate Ochrobactrum phages. Front. Microbiol. 2017, 8, 1207. [Google Scholar] [CrossRef] [PubMed]
- Hofacker, I.L.; Fontana, W.; Stadler, P.F.; Bonhoeffer, S.; Tacker, M.; Schuster, P. Fast folding and comparison of RNA secondary structures. Monatsh Chem. 1994, 125, 167–188. [Google Scholar] [CrossRef]
- Macke, T.J.; Ecker, D.J.; Gutell, R.R.; Gautheret, D.; Case, D.A.; Sampath, R. RNAMotif, an RNA secondary structure definition and search algorithm. Nucleic Acids Res. 2001, 29, 4724–4735. [Google Scholar] [CrossRef]
- Kaas, R.S.; Leekitcharoenphon, P.; Aarestrup, F.M.; Lund, O. Solving the problem of comparing whole bacterial genomes across different sequencing platforms. PLoS ONE 2014, 9, e104984. [Google Scholar] [CrossRef] [PubMed]

| Y. enterocolitica | vB_YenM_P281 28 °C | vB_YenM_P281 37 °C | vB_YenP_Rambo 28 °C | vB_YenP_Rambo 37 °C |
|---|---|---|---|---|
| B4/O:3 (n = 18) | 18 | 16 | 16 | 18 |
| B2/O:9 (n = 19) | 0 | 18 | 19 | 19 |
| B2/O:5,27 (n = 17) | 15 | 17 | 15 | 17 |
| 1B/O:8 (n = 8) | 7 | 8 | 0 | 0 |
| Total (n = 62) | 40 (62) | 59 (62) | 50 (62) | 54 (62) |
| Y. enterocolitica (biovar 1A) | vB_YenM_P281 28 °C | vB_YenM_P281 37 °C | vB_YenP_Rambo 28 °C | vB_YenP_Rambo 37 °C |
| O:5 (YE17/18) | − | +++ | − | +++ |
| O:5 (YE65/14) | ++ | +++ | + | +++ |
| O:5 (YE129/15) | − | + | − | − |
| O:6,31 (YE30/12) | ++ | +++ | − | +++ |
| O:7,8 (YE21/12) | − | +++ | − | − |
| O:7,8 (YE29/16) | − | ++ | − | − |
| O:8 (YE03/13) | − | ++ | − | − |
| O:13,17 (YE15/07) | − | +++ | − | ++ |
| O:27 (YE80/16) | +++ | +++ | + | +++ |
| O:27 (YE83/16) | + | ++ | − | +++ |
| Total (n = 10) | 4 (10) | 10 (10) | 2 (10) | 6 (10) |
| Y. pseudotuberculosis | vB_YenM_P281 28 °C | vB_YenM_P281 37 °C | PY100 28 °C | PY100 37 °C |
|---|---|---|---|---|
| O:1a (n = 12) | 7 | 10 | 8 | 10 |
| O:1b (n = 8) | 3 | 8 | 7 | 8 |
| O:2a (n = 2) | 0 | 0 | 0 | 0 |
| O:2b (n = 1) | 1 | 1 | 1 | 1 |
| O:3 (n = 2) | 1 | 1 | 2 | 2 |
| O:4b (n = 1) | 1 | 1 | 1 | 1 |
| O:5a (n = 2) | 0 | 1 | 0 | 1 |
| O:6 (n = 4) | 1 | 3 | 3 | 3 |
| O:9 (n = 2) | 1 | 2 | 1 | 1 |
| Unknown O-type (n = 21) | 16 | 19 | 18 | 20 |
| Total (n = 55) | 31 (55) | 46 (55) | 41 (55) | 47 (55) |
| Yersinia Species | Strain ID | VB_YenP_Rambo | VB_YenM_P281 |
|---|---|---|---|
| Y. intermedia | DSM 18517 | − | − |
| Y. frederiksenii | DSM 18490 | +++ | + |
| Y. bercovieri | DSM 18528 | +++ | + |
| Y. similis | DSM 18211 | − | − |
| Y. wautersii | DSM 27350 | + (S) | +++ (S) |
| Y. aldovae | DSM 18303 | − | − |
| Y. aleksiciae | DSM 14987 | − | − |
| Y. pekkanenii | DSM 22770 | − | − |
| Y. rohdei | DSM 18270 | − | − |
| Y. masssiliensis | DSM 21859 | − | − |
| Y. kristensenii | DSM 18543 | +++ | + (S) |
| Y. nurmii | DSM 22297 | − | − |
| Y. ruckeri | DSM 18506 | − | − |
| Y. mollaretii | DSM 18520 | − | − |
| Total (n = 14) | 4 (14) | 4 (14) |
Publisher’s Note: MDPI stays neutral with regard to jurisdictional claims in published maps and institutional affiliations. |
© 2021 by the authors. Licensee MDPI, Basel, Switzerland. This article is an open access article distributed under the terms and conditions of the Creative Commons Attribution (CC BY) license (https://creativecommons.org/licenses/by/4.0/).
Share and Cite
Hammerl, J.A.; Barac, A.; Erben, P.; Fuhrmann, J.; Gadicherla, A.; Kumsteller, F.; Lauckner, A.; Müller, F.; Hertwig, S. Properties of Two Broad Host Range Phages of Yersinia enterocolitica Isolated from Wild Animals. Int. J. Mol. Sci. 2021, 22, 11381. https://doi.org/10.3390/ijms222111381
Hammerl JA, Barac A, Erben P, Fuhrmann J, Gadicherla A, Kumsteller F, Lauckner A, Müller F, Hertwig S. Properties of Two Broad Host Range Phages of Yersinia enterocolitica Isolated from Wild Animals. International Journal of Molecular Sciences. 2021; 22(21):11381. https://doi.org/10.3390/ijms222111381
Chicago/Turabian StyleHammerl, Jens A., Andrea Barac, Philipp Erben, Julius Fuhrmann, Ashish Gadicherla, Franziska Kumsteller, Anne Lauckner, Felix Müller, and Stefan Hertwig. 2021. "Properties of Two Broad Host Range Phages of Yersinia enterocolitica Isolated from Wild Animals" International Journal of Molecular Sciences 22, no. 21: 11381. https://doi.org/10.3390/ijms222111381
APA StyleHammerl, J. A., Barac, A., Erben, P., Fuhrmann, J., Gadicherla, A., Kumsteller, F., Lauckner, A., Müller, F., & Hertwig, S. (2021). Properties of Two Broad Host Range Phages of Yersinia enterocolitica Isolated from Wild Animals. International Journal of Molecular Sciences, 22(21), 11381. https://doi.org/10.3390/ijms222111381

